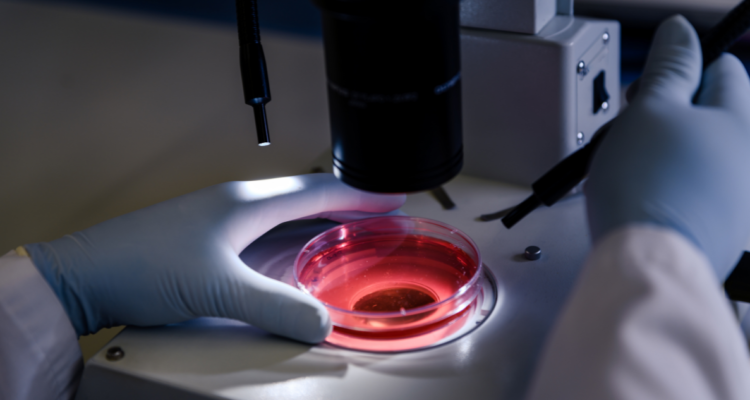
Células CAR-T : nuevo avance para tratar el cáncer

El mundo sigue buscando curas contra el cáncer, la enfermedad que es foco de investigaciones científicas a nivel internacional. Al mismo tiempo, los médicos se atreven cada vez más a aplicar nuevos tratamientos y, por sobre todo, los pacientes quieren opciones eficaces para vencer esta enfermedad y continuar sus vidas. El último avance médico es células CAR-T, un proceso que consiste en recolectar linfocitos “T”, los que son modificados genéticamente.
viña 2025:
ahora
presentándose
{{liveArtist.name}}
¿Cómo evaluarías su presentación?
Opinión > Opinión Cómo publicar en Opinión
Lunes 17 julio de 2023 | 18:25
Células CAR-T : nuevo avance para tratar el cáncer
Columna de Opinión
Nuestra sección de OPINIÓN es un espacio abierto, por lo que el contenido vertido en esta columna es de exclusiva responsabilidad de su autor, y no refleja necesariamente la línea editorial de BioBioChile
Freepik (CCO)
visitas
Nuestra sección de OPINIÓN es un espacio abierto, por lo que el contenido vertido en esta columna es de exclusiva responsabilidad de su autor, y no refleja necesariamente la línea editorial de BioBioChile
visto ahora
> {{ post.trust_project_tooltip.etiqueta }}
{{ post.post_date_txt }} | {{ post.post_hour }}
Columna de Opinión
Nuestra sección de OPINIÓN es un espacio abierto, por lo que el contenido vertido en esta columna es de exclusiva responsabilidad de su autor, y no refleja necesariamente la línea editorial de BioBioChile
Editorial Bío Bío
La Verdad Se Cuenta
visitas
Noticia en Desarrollo
Estamos recopilando más antecedentes sobre esta noticia, quédate atento a las
actualizaciones.
Alerta de Spoiler
Este artículo podría contener información clave sobre la trama de un libro, serie o
película.
Advertencia de imágenes explícitas
¡Cuidado! Las imágenes de este artículo pueden herir la sensibilidad de algunas personas.
VER RESUMEN
Resumen generado con una herramienta de Inteligencia Artificial desarrollada por BioBioChile y revisado por el autor de este artículo.
{{ post.resumen_de_ia }}
Este artículo describe un proceso judicial en curso
Existe la posibilidad de que los cargos sean desestimados al finalizar la investigación, por
lo cual NO se debe considerar al o los imputados como culpables hasta que la Justicia
dicte sentencia en su contra.
(Artículo 04 del Código Procesal Penal)
(Artículo 04 del Código Procesal Penal)
Violencia contra la mujer
Si eres víctima o testigo de violencia contra la mujer, denuncia al
149 de Carabineros, recibe orientación llamando al
número corto 1455 del Sernameg o pulsa para
usar el chat de orientación Sernameg
Suicidio
Si necesitas ayuda psicológica especializada o conoces a alguien que la requiera, el Ministerio
de Salud tiene un teléfono de ayuda atendida por profesionales todos los días del año y las 24 horas,
marcando desde celulares el *4141. Además, puedes recurrir a Salud Responde en el 600 360 7777.
Las personas sordas pueden recibir asistencia ingresando a
este enlace.
Transporte privado
Las aplicaciones de transporte privado pagado aún no se encuentran normadas por la legislación chilena.
Estudio científico
Este artículo se basa en un estudio científico que puede ser sometido a nuevas pruebas para ser validado o descartado. Sus resultados NO deben considerarse concluyentes.







 Enviando corrección, espere un momento...
Enviando corrección, espere un momento...